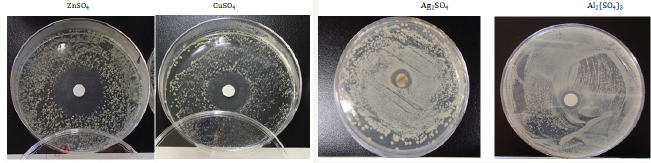
Click here to view Large Figure 1

Ishida T*
Life and Environment Science Research Division, Japan
*Corresponding author: Ishida Tsuneo, 2-3-6, Saido, Midoriku, Saitama city, Saitama prefecture 336-0907, Japan
Submission: November 08, 2017; Published: December 21, 2017
Volume1 Issue1 November 2017
From the results on antibacterial activities, the killing mechanisms have become clear that bacteriolysis for S. aureus peptidoglycan(PGN) cell wall is due to the inhibition of PGN elongation by the activities of PGN autolysins of amidases, and the other, for E. coli cell wall are due to destruction of outer membrane structure by degrading of lipoprotein at C-, N-terminals, owing to PGN formation inhibition by activities of PGN autolysins of amidase and carboxypeptidase-transpeptidase. Clioquinol, NF-kB, Zinc-mediated cancer chemoprevention can be expected to be efficacious in the prevention and treatment of several cancers. Zinc which is essential for many cellular processes plays a potential role in signal pathway linked with various physiological actions. The imbalances in Zn homeostasis cause disease states including such as diabetes, cancer, and Alzheimer's disease. The accumulation of zinc also inhibits mitochondrial terminal oxidation and respiration. Zn2++ ions provide formation of fluorescent product after reaction with -SH groups of thiols,

In cancer cell, Zn(II)S+-complex ion may be formed and the complex is binding with S-atom. Zinc is known to have systemic effects such as regulation of the immune system as well as direct cellular effects resulting in regulation of gene expression. Zinc can inhibit apoptosis induced by both chemical and death-receptor agonists. Apoptotic effects of zinc because zinc is reported to both induce apoptosis in some cancers and to protect other cancer cells against apoptosis induced by other factors.
Autophagy as self-eating is involved in the bulk degradation, in which autophagy is highly conserved homeostatic mechanism for the degradation and recycling of bulk cytoplasm, organelles, and long-lived proteins through the lysosomal machinery. Degradation of the mutant protein by Zn2+ ion mediated and induced autophagy lead to cell death in cancer cell line. Zinc played a key role in the regulation of EMT and metastatic behaviors, that zinc-induced EMT increases the intracellular superoxide anion and induce EMT phenotypes in lung cancer cells by up-regulating of EMT markers and down-regulating of E-cadherin protein. Thus, zinc oxide, Zn-complex compound and Zn2+-chelation induced cancer and tumor cells can occur in adaptive tumor immunity, apoptosis, anti-angiogenic effect, also through reactive oxygen species (ROS). Damage by Zn-DNA reaction may be occurred by Zn substitution into hydrogen bond within DNA base pairs.
Keywords: Zinc(II) ions; Degradation of mutant protein; Autophagy; Angiogenesis; Zinc chelation; Metastatic dissemination; DNA damage
Zinc is required in the diet of human being in trace quantities, which is approximately 15mg Zn/day and the average amount of Zn in the adult body is about 1.4~2.3g [1]. Zinc deficiency increases the levels of lipid peroxidation in mitochondrial and microsomal membranes and the osmotic fragility of erythrocyte membrane, while the presence of zinc prevents lipid peroxidation and thus plays an important role in protecting the cells from oxidative stress. Zn2+ dysregulation, zinc deficiency, and zinc excess are connected with various pathologies in the form of diseases of the immune gastrointestinal, endocrine, and nervous system, heart failures, hematologic diseases, and neoplasms. Zinc is known to be an essential component for DNA-binding proteins with Zn fingers, as well as Cu/Zn superoxide dismutase(SOD) and various proteins involved in DNA damage and repair [2,3]. Zn also is critical for cell proliferation, cell cycle regulation, differentiation and apoptosis [4]. The other, the antioxidant and anti-carcinogenesis mechanisms associated with Zn homeostasis play an inhibitory role on neoplastic cell growth. Zinc(II) ion has been known for many years to inhibit apoptosis.
Zinc element in such as zinc nitrate and zinc sulfate aqueous solutions, Zn2+ ion is stable in the electrolytic solution of the presence as free Zn(II) ion, which is reacted with biological cell. The other, in the case such as crystallite surface ZnO, Zn2+ ion released is present as free zinc ion. Hence, these zinc ions influence the major stage of the processes of initiation, promotion, progression, and metastasis of tumorigenesis. Given the importance of these channels and signaling pathways in cell proliferation, migration and metastasis, appreciating the impact of Zn deficiency on the functions of these channels in cancer cells is exigent priority [5]. According to physiology and pathology of Zn2+ ions [6], Zn(II) dysregulation, deficiency and over-supply are connected with various diseases, DNA synthesis, neurotransmission, and apoptosis, particularly cancer 98%of human body Zn(II) is localized in the intracellular compartment, where zinc(II) is bound with low affinity to metallothionein (MT). MT protects cells against oxidative stress, because it cooperates with reduced glutathione (GSH). MT together with zinc(II) affects apoptosis and proliferation, in which elevated Halo-Inhibitory susceptibility test results serum level of MT in a number of malignancies, among others in breast, and prostate. Antibacterial activity of zinc(II) ion is very high against Gram-positive and negative bacteria [7,8]. Anticancer activity of Zn2+ ions against cancer and tumor cells, in which how behaviors are indicated in the development and the progression of cancer and tumor cells. In this review, the anticancer activities by Zinc(II) ion solution against cancer and tumor cells were investigated on cancer prevention, tumor formation and growth, proliferation, invasion, and metastasis, in which the systemic effects of zinc(II) ions are involved in the status of zinc homeostasis, the regulation of apoptosis in malignant, the cancer cell proliferation and growth, and the angiogenesis in cancer and tumor cells.
Figure 1: Sample appearance of halo inhibitory zone tests.
Halo antibacterial tests have been carried out for the sulfate aqueous solutions against Staphylococcus epidermidis. Figure 1 shows the sample surface appearances of inhibitory zone after antibacterial halo-tests for sulfate solutionsagainst Staphylococcus epidermidis. From these observations, the antibacterial order is Zn2+>Cu2+>Ag+>Al3+, in which Zn2+ ions indicate the highest antibacterial effect. The killing mechanism against bacteria has become clear that bacteriolysis and destruction of S. aureus peptidoglycan (PGN) cell wall by Zn2+ ions are due to the inhibition of PGN elongation by the activities of PGN autolysins of amidases. The other, bacteriolysis of E. coli cell wall by Zn2+ ions are due to destruction of outer membrane structure by degrading of lipoprotein at C-, N-terminals, owing to PGN formation inhibition by activities of PGN autolysins of amidase and carboxypeptidase- transpeptidase [9].
Many enzymes and proteins utilize first transition and GroupIIB elements to carry out their biological functions and especially, zinc is the most widely used of these elements. Proper intake of dietary nutrient is considered crucial for preventing the initiation and the promotion of carcinoma [10]. Zinc has been ascribed role in oxidative stress, DNA damage repair, metabolism and interaction of malignant cells, particularly in apoptosis. Zinc-mediated cancer chemoprevention can be expected to be efficacious in the prevention and treatment of several cancers [11]. Leukotriene A4 hydrolase(LTA4H) having a bifunctional zinc enzyme with the activities of epoxide hydrolase and amino peptidase, functions as a chemo attractant and an activator of inflammatory cells. Bestatin, an LTA4H inhibitor, suppresses tumorigenesis in this animal model. Since LTA4H has long been regarded as an anti-inflammatory target, this LTA4H is recommended as a target for prevention and therapy of cancer, especially those associated with chronic inflammation [11].
Zinc which is essential for many cellular processes, plays a potential role in signal pathway linked with various physiological actions. The imbalances in Zn homeostasis cause disease states including such as diabetes, cancer, and Alzheimer's disease. In breast cancer patients, the level of Zn has been found to be lower in serum than healthy subjects and elevated in malignant tissues, whereas in liver, prostate and gallbladder cancers, the Zn level in the malignant tissues has been found to be decreased. Zn is implicated in breast cancer development. The intracellular Zn level is controlled by several protein molecules called zinc-binding protein and zinc transporters [12].
Zinc migration in cancer cells occurs as zinc transporters and dysregulated Zn2+; ion channels, in which Zn accumulation in tumor tissue correlates with increased level of Zn importing proteins. Further, aberrant expression of Zn transporters in tumors correlates with malignancy. Zn homeostasis is tightly controlled by regulating the flux of Zn across cell membranes through specific transporters, i.e. Zn Transporter (ZnT) and Zrt-, Irt-like Protein (ZIP) family proteins. Zn deficiency and malfunction of Zn transporters have been associated with many chronic diseases including cancer [5].
The accumulation of zinc also inhibits mitochondrial terminal oxidation and respiration. Zn2+ ions provide formation of fluorescent product after reaction with -SH groups of thiols [13],

In cancer cell, Zn(II)S+-complex ion may be formed and the complex is binding with S-atom. Zinc is known to have systemic effects such as regulation of the immune system as well as direct cellular effects resulting in regulation of gene expression. Zinc can inhibit apoptosis induced by both chemical and death-receptor agonists. Apoptotic effects of zinc because zinc is reported to both induce apoptosis in some cancers and to protect other cancer cells against apoptosis induced by other factors. Inhibitors of matrix metalloproteinases (MMPs) enzymes are widely related in the processes of tumor growth, angiogenesis, invasion and metastasis [14]. The extracellular MMP-2 and MMP-9 possessed zinc-binding ability is attention as anti-metastatic or antitumoral drugs [15]. Gelatinase class MMPs of MMP-2 and MMP-9 metalloproteinases, have the ability to degrade collagenVI that makes up the basal lamina, and are relevant in the acquisition of the invasive phenotype of malignant neoplasms. These MMPs become clear that increase in zinc concentrations in cellular compartments and the reduction of this trace element in the blood of patients with breast cancer appear to alter the activity of metalloproteinases 2 and 9, contributing to the occurrence of malignancy. The effectiveness and the factors of these inhibitors for breast carcinoma are considered that relating with the reactions of zinc ion complex compounds and MMPs activation in the pathogenesis of breast cancer [16].
Lysosome: Intracellular Zn2+ was found to be concentrated in lysosomes, indicating that lysosomal integrity was disrupted after addition of clioquinol and zinc to the cell. Thus, clioquinol generates free zinc in lysosomes, leading to their disruption and apoptotic cell death [17]. Further, mechanism of clioquinol/ZnCl2 -induced apoptotic cell death remains to be elucidated.
Mitochondria: The accumulation of high intracellular zinc levels in specific prostate cells, where it can inhibit aconitase and truncate the citric acid cycle, results in the induction of apoptosis and the inhibition of cell growth. The apoptotic effect is due to zinc induction of mitochondrial apoptogenesis. The cell specificity of zinc induction of apoptogenesis is dependent on the ability of the cells to accumulate high levels of intracellular zinc and on the ability of the mitochondria to respond to the direct effect of zinc [18]. By investigating mobile Zn2+ in mitochondria, in contrast to healthy epithelial prostate cells, tumorigenic cells are unable to accumulate mobile zinc within their mitochondria [19]. The apoptogenic effect is due to a direct effect of zinc on mitochondria that results in the release of cytochrome c. The cytosolic source of mitochondrial zinc is derived from mobile reactive Zn-Ligands that are 10kDa or less and are capable of permeating the outer mitochondrial membrane pores. These lower molecular weight Zn-Ligands such as Zn- Metallothionen, Zn-Citrate, Zn-Histidine formations.
Zinc could play a central role, regulating apoptosis and autophagy as well as immune cell functions, when the cancer cells are stressed (such as genomic stress, nutrient stress, oxidant stress). Zinc is crucial for normal development and function of cells mediating innate immunity, neutrophils, and NK cells. The ability of zinc to function as an anti-oxidant suggests that it has a role in the prevention of free radical-induced injury during inflammatory processes. There are many pathways involved in the inflammatory processes that the nuclear factor kappa-B (NF-kB)is one of the main inflammatory pathways, which regulate the genes controlling apoptosis, cell adhesion, proliferation, tissue remodeling, the innate and adaptive immune responses, inflammatory processes, and cellular-stress responses. In zinc-dependent NF-kB signaling, zinc supplementation influences NF-kB via the alteration of protein A20 activity and zinc is acting on the NF-kB pathway at the level of A20 to further enhance its inhibitory effect, in which zinc supplementation prevent abdominal aortic aneurysm formation in rat by induction of A20-mediated inhibition of the NF-kB canonical pathway. The physiological reconstitution of zinc restrains immune activation, whereas zinc deficiency provokes a systemic increase in NF-kB activation, in which zinc exerts anti-inflammatory activity and its antioxidant. Thus, it influences multiple aspects of the constitute the source of mobile reactive zinc for transport into the mitochondria [20]. Thus, free Zn2+ ions are not required for the transport process, in which is the direct intermolecular exchange of zinc from the donor Zn-Ligand to the recipient putative uptake transporter protein.
Nucleus: Further, for zinc ion into nucleus of cancer cell, immune cytochemical localization and immune-blotting assay demonstrated that zinc induces the nuclear translocation of MTF-1- FLAG, expressed from the cytomegalovirus promoter in transiently transfected dko7(MTF-1 double knockout) cells [21].
DNA damage by Zn-DNA reaction: Zn2+ substitutions into hydrogen bonds within DNA base pairs; A=T,G=C are shown in Figure 2, indicating Zn ion-complex immune system, including haematopoiesis, innate immunity, adaptive immune response, and processes involved in immune regulation [22].
Degradation of cancer protein by Zn2+ through autophagy:
Normal cellular growth and development require a balance between protein synthesis and degradation. Eukaryotic cells have two major avenues for degradation: Proteasome and Autophagy [23]. Autophagy as self-eating is involved in the bulk degradation, in which autophagy is highly conserved homeostatic mechanism for the degradation and recycling of bulk cytoplasm, organelles, and long-lived proteins through the lysosomal machinery. While functional autophagy prevents tumor growth initiation, its pro-survival effect may allow transformed cells to resist against progression of diseases. Degradation of the mutant protein by Zn2+ ion mediated and induced autophagy lead tocell death in cancer cell line [24,25] and activation of NKG2D ligands in tumor immunity [26]. Further, autophagy in tumor immune microenvironment can affect immune responses inside the tumors. The autophagy in tumor cells plays dual roles of immunoglobulins and immune- related cells in tumor development [27].
Figure 2:
Zn2+ substitution into the triple and double hydrogen bonds in DNA base-pairing G:C, A:T pairsa)
G=C base pair, regular octahedron, 6-coodinated structure, Zn complex formation (stable)
b) A=T base pair, planar square, 4-coodinated structure, Zn complex formation (unstable).

Angiogenesis forming new capillaries from existing vasculature has a complex multistep process comprised of endothelial cell proliferation, migration, differentiation and remodeling of the extracellular matrix [28]. Angiogenesis refers to the budding of new capillary branches from existing bloods vessels. Capillaries are formed by endothelial cells creating primitive tubules, which are then further supported and augmented by interactions with vascular pericytes. Angiogenesis is involved not only with normal and developmental physiological processes, but also in the development of a number of pathological conditions, including rheumatoid arthritis, psoriasis, retinopathies and cancer. Angiogenesis is a multi-step process: Step One; Endothelial cell activation by growth factors including VEGF, bFGF, Step Two; Degradation of the capillary wall by extracellular proteinases (matrix metalloproteinases), Step Three; Formation of a branch point in the vessel wall, Step Four; Migration of endothelial cells into the extracellular matrix towards the angiogenic stimulus, Step Five; Re-organization of endothelial cells to form tubules with a central lumen. The process of angiogenesis is controlled by pro- angiogenic chemical signals in the body which stimulate both the formation of new blood vessels and the repair of damaged ones. The chemical signals called angiogenesis inhibitors hinder the blood vessel formation. These pro- and anti-angiogenic chemical signals are normally balanced in a way that blood vessels form only when and where this balance is disrupted in favor of angiogenesis [29]. A blood supply is necessary for tumors to grow and spread to distant sites. Tumor progression is regulated by production of much pro- and anti-angiogenic factors, which are necessary for further outgrowth and metastasis of the tumor.
Cu-Zn superoxide dismutase (SOD) is a key enzyme in the dismutation of the potentially toxic superoxide radicals into hydrogen peroxide and dioxygen. Altered activity of SOD effects the angiogenic process, because angiogenesis is characterized by proliferating endothelial cells and reoxygenation [30]. Zinc chelation is involved in the inhibitory effect of ellagic acid (EA) on matrix-induced tube formation and migration of human endothelial cells [31]. EA can inhibit the activity and the secretion of MMP-2 in human vascular endothelial cells likely mediated by the induction of RECK expression. EA also inhibits the tube formation and migration of human vascular endothelial cells in a dose-dependent manner. These anti-angiogenic effects caused by EA may also help to reduce the oxidation stress, particularly those produced from zinc-induced oxidation in the cells which deserved further investigation in the future. The oxidative stress also represents an important stimulus that widely contributes to tumor angiogenesis mediating the angiogenic switch that can be produced by cancer cells and thus contribute to neoplastic transformation and angiogenesis [32]. The zinc chelation of EA is related to its angiogenic effects by inhibiting MMP-2 activity, tube formation and cell migration of vascular endothelial cells [33]. Hence, the roles of zinc ions have important MMP activity, tube formation, and cell migration in angiogenesis process. Zinc ions induced inhibitions of blood vessel formation and regulation of angiogenesis [34].
Regulation of apoptosis for malignant tumor/inhibition of proliferation
Zinc is known to have systemic effects such as regulation of the immune system as well as direct cellular effects resulting in regulation of gene expression [35], bioenergetics, signal transduction and cell invasion. The zinc effects are involved in the regulation of apoptosis in malignant cells and the effects on cancer cells must be viewed from the perspective of physiological regulation for zinc homeostasis [36]. The other, the prostate cells are unable to accumulate zinc (II) ions in high levels, because the feature of prostate cells is lost during carcinogenesis [13]. Zinc ions can significantly contribute to the progression of tumor disease and to the ability of prostate cell lines to metastasize, where several compounds in order to be zinc-presence in the cancer cells act as an inhibitor of apoptosis [13]. It prevents both apoptosis dependent on caspases and oxidative necrosis. Consequently, these effects of zinc also impose anti-tumor action, in which the ability of prostate cells to accumulate zinc is due to the expression and activity of the zinc uptake transporter, ZIP1 as a tumor suppressor gene in prostate cancer [20].
Invasion process and inhibition of invasion
Cancer cells invade other tissues either by moving collectively as epithelial sheets, detached clusters, and as single cells via mesenchymal or amoeboid cell types [37]. The tumor cell migration and invasion are critical steps in the cancer metastatic cascade [38]. Tumor cells interact activity with the tumor microenvironment (TME) with many physiological events such as cancer cell, in which the tumor cell-TME interactions become important [39]. By the activation of tumor cell-TME interaction, promotion of inhibition for tumor cell migration and invasion proceed on potential protective role and conditioning tumor microenvironment of zinc [40]. MMPs play a crucial role in the development and metastatic spread of cancer. Caffeoyl pyrrolidine derivative LY52 with zinc-dependent endopeptidases MMPs inhibits tumor invasion and metastasis [41]. This LY52 may be a candidate compound for anti-invasion and antimetastasis via suppression of MMP-Zn activity.
Inhibition of metastasis
Metastasis has a multi-step cell-biological process of the invasion-metastatic cascade, which involves
a. The local infiltration of tumor cells into the adjacent tissue,
b. Transendothelial migration of cancer cells into vessels known as intravasation,
c. Survival in the circulatory system,
d. Extravasation and
e. Subsequent proliferation in competent organs leading to colonization [42].
EMT-Zn is considered a critical augmenting process of cancer metastasis of above-described stage [43]. Zinc played a key role in the regulation of EMT and metastatic behaviors, that zinc-induced EMT increases the intracellular superoxide anion and induce EMT phenotypes in lung cancer cells by up-regulating of EMT markers and down-regulating of E-cadherin protein [43]. The other, the structure of the catalytic domain of Golgi a-mannosidaseII(GMII; mannosyl oligosaccharide 1,3-1,6-a-mannosidaseII; EC 3.2.1.114) provides the basis for it zinc ion-mediated specificity for mannose, as well as insight into its reaction mechanism [44], in which GMII inhibits growth and metastasis of cancer cells [45].
Zinc-chelation of ellagic acid also contributes to the anti- angiogenic effect by inhibiting MMP-2 activity, tube formation and cell migration of vascular endothelial cells, not interacting with the catalytic zinc ion [46]. Regarding as physiology and pathology of zinc(II) ions, ZIP6 is positively regulated by estrogens and depletion of ZIP10 transporter inhibits the cell migration of highly metastatic breast cancer, in which suggests a potential path to regulate metastatic potential of breast cancer, owing to identifying of other mechanism leading to zinc(II), finding of mechanism leading to zinc/metallothionein misbalance, and identifying of effects on prostate and breast cancer pathogenesis [47]. MMPs activities through zinc ions and zinc chelation can prevent ongoing spontaneous metastases dissemination from the existing primary bone tumor [47], using as inhibition of disseminated metastasis [48].
Zinc compounds have many biological activities, including the ability to induce apoptosis in cancer cells. Zinc oxide nanoparticles are attributed to vital role in cancer eradiation, that an important advantage of the targeted tumor treatment is lowering the cyto and genotoxicity of active substance [49]. MMPs remain a viable target for cancer therapeutics. The role of MMPs in cancer, clinical trials for MMP inhibitors, and novel approaches to targeting MMPs in cancer [50]. Clioquinol targets NF-kB including zinc and lysosome pathways independently, favoring further development of clioquinol as a novel anticancer agent [50]. The p53 pathway of rapid advances has been developed in small molecule protein-protein interactions inhibitors, in which now increased understanding needed is p53 that is activated selects its response between reversible growth arrest apoptosis or senescence [51]. Zrt-, Irt-like protein (Zip) and zinc transporter (ZnT) or both zinc and metallothioneins (MTs) have important roles for anti-cancer activities of cancer and tumor cells [52]. These Zn compounds as multipurpose compounds, biological roles in homeostasis, proliferation and roles in immunity and in chronic diseases, such as cancer, brain tumor. Table 1 represents anti-cancer activities of Zn2+ ions for cancer prevention, promotion, progression, proliferation, invasion, and metastasis against cancer and tumor cells.
Bacteriolyses for S. aureus peptidoglycan (PGN) cell wall are due to the inhibition of PGN elongation by the activities of PGN autolysins of amidases, and the other, for E. coli cell wall are due by activities of PGN autolysins of amidase and carboxypeptidase- to destruction of outer membrane structure by degrading of transpeptidase. lipoprotein at C-, N-terminals, owing to PGN formation inhibition by activities of PGN autolysins of amidase and carboxypeptidase-transpeptidase.
Table 1: Anti-cancer activities of Zn2+ ions for the initiation, progression, proliferation, invasion, and metastasis against cancer and tumor cells.

Zinc-mediated cancer chemoprevention can be expected to be efficacious in the prevention and treatment of several cancers. Zinc which is essential for many cellular processes, plays a potential role in signal pathway linked with various physiological actions. The imbalances in Zn homeostasis cause disease states including such as diabetes, cancer, and Alzheimer's disease. The accumulation of zinc also inhibits mitochondrial terminal oxidation and respiration. Zn2+ ions provide formation of fluorescent product after reaction with -SH groups of thiols,
In cancer cell, Zn(II)S+-complex ion may be formed and the complex is binding with S-atom. Zinc is known to have systemic effects such as regulation of the immune system as well as direct cellular effects resulting in regulation of gene expression. Zinc can inhibit apoptosis induced by both chemical and death-receptor agonists. Apoptotic effects of zinc because zinc is reported to both induce apoptosis in some cancers and to protect other cancer cells against apoptosis induced by other factors. Degradation of the mutant protein by Zn2+ ion mediated and induced autophagy lead to cell death in cancer cell line. Eukaryotic cells have two major avenues for degradation: Proteasome and Autophagy. Autophagy as self-eating is involved in the bulk degradation, in which autophagy is highly conserved homeostatic mechanism for the degradation and recycling of bulk cytoplasm, organelles, and long-lived proteins through the lysosomal machinery. Zinc played a key role in the regulation of EMT and metastatic behaviors, that zinc-induced EMT increases the intracellular superoxide anion and induce EMT phenotypes in lung cancer cells by up-regulating of EMT markers and down-regulating of E-cadherin protein. Thus, zinc oxide, Zn- complex compound and Zn-chelation induced cancer and tumor cells can occur in adaptive tumor immunity, apoptosis, anti- angiogenic effect, also through ROS.
© 2017 Ishida T. This is an open access article distributed under the terms of the Creative Commons Attribution License , which permits unrestricted use, distribution, and build upon your work non-commercially.
a Creative Commons Attribution 4.0 International License. Based on a work at www.crimsonpublishers.com.
Best viewed in